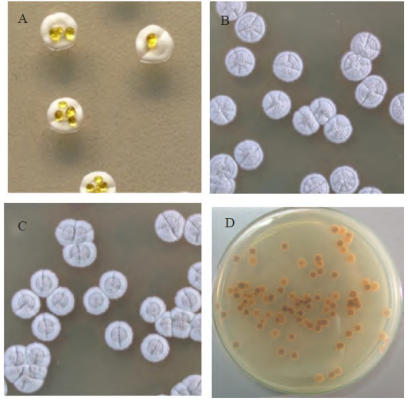

米尔贝霉素A3和A4高产菌的理性选育
来源: 作者: 发布时间:2019-08-30 11:01 浏览量:406
本期为您推荐浙江海正药业股份有限公司,浙江省抗真菌药物重点实验室白骅研究团队发表在《中国抗生素杂志》上的一篇文章:米尔贝霉素A3和A4高产菌的理性选育。
文章摘要内容如下:
米尔贝霉素(milbemycin)于1967年在吸水链霉菌S.hygroscopicus subsp.aureolacrimosus的发酵液中首次发现,其结构属十六元大环内酯类化合物,是生态友好型天然产物农药。米尔贝霉素A3和A4组分混合物(A3:A4=3:7)产品被用做植物虫害的防治,但由于产品对A3/A4的比例(3:7)有着严格的要求且一般菌种很难满足这一比例,通过提取工艺的优化来解决比例问题会导致生产成本过高,且米尔贝霉素A3/A4在结构上非常相似,如果能够实现A3和A4单一组分的生产,且进一步提高发酵单位,降低成本,则可避开多组分产品的市场限制,推动该类产品在国内的使用。
本研究以吸水链霉菌CGMCC7677为出发菌,通过紫外、甲基磺酸乙酯与常压室温等离子体等单独诱变或组合诱变,结合含甘氨酸、利福平、乙酸钠和3-溴丙酮酸的抗性平板进行筛选,最终得到米尔贝霉素突变株75-22和95-23。在不改变培养基组成和培养条件的情况下,75-22在50L发酵罐中培养360h,米尔贝霉素A4(1)的生产能力提高了5倍,米尔贝霉素A4(1)的含量也从70%提高至80%以上。95-23在50L发酵罐中培养360h,米尔贝霉素A3(2)的生产能力提高了10倍,米尔贝霉素A3(2)的含量提高至70%以上。主产单一组分菌种的获得,可进一步扩大米尔贝霉素的应用研究范围,也为米尔贝霉素的产业化提供了优良的菌种。
文章精彩内容如下:

图2 米尔贝霉素生产菌CGMCC7677选育谱系图
GlyR:甘氨酸抗性;RifR:利福平抗性;AcetR:乙酸钠抗性;3-BropyR:3-溴丙酮酸抗性
图3 选育过程中形成的两种形态突变株
A:原始菌种;B:1组分高比例菌株;C:2组分高比例菌株;D:两种形态突变株在平板上生长时的背面差异

图6 突变株75-22在50L发酵罐中的代谢曲线

图7 突变株95-23在50L发酵罐中的代谢曲线
